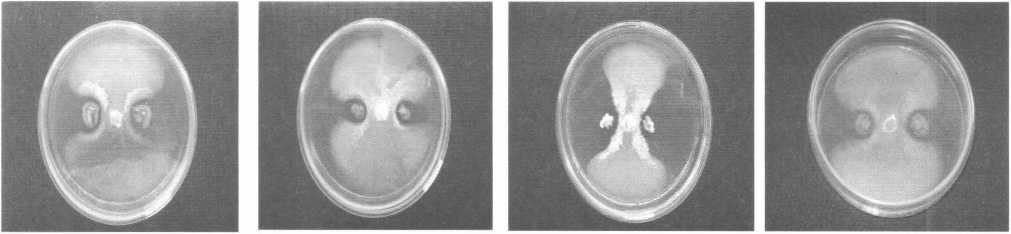

SELEKSI DAN PEMANFAATAN ACTINOMYCETES SEBAGAI MIKROBA ANTAGONIS YANG RAMAH LINGKUNGAN TERHADAP Fusarium oxysporum f.sp. cubense SECARA IN VITRO
on
ECOTROPHIC • 5 (2) : 104 - 107
ISSN: 1907-5626
SELEKSI DAN PEMANFAATAN ACTINOMYCETES SEBAGAI MIKROBA ANTAGONIS YANG RAMAH LINGKUNGAN TERHADAP
Fusarium oxysporum £sp. cubense SECARA IN VITRO
I MADE SUDARMA
Sta[ Dasen Jurusan Agroekoteknologi, Fakultas Pertanian Universitas Udayana E-mail. Sudarma_made@yalwo.com
ABSTRACT
A total of 119 different actinomycete isolate were recovered from banana crop habitats with and without Fusarium wilt disease symptom. These were than assessed for their antagonist ability against Fusarium oxysporum £sp. cubense (Foe) in vitro. Results indicated that four of all actinomycete isolate active against Foe. The four of actinomycete isolates were Streptomyces sp. l (AAo4), Streptomyces sp.2 (AAo32 ), Streptomyces sp.3 (AAo33) and Streptomyces sp. 4 (AAo35). It was can inhibit the Foe mycelium growth, 79,63%, 72,22%, 78,89% and 72,22% respectively. After tested with the 3 times replication, the four Streptomyces spp. isolate effective to control the Foe that attack Bali banana cultivars, such as Susu, Saba, Raja and Ketip.
Keywords: Fusarium, Banana
PENDUHULUAN
Pisang merupakan salah satu tanaman hortikultura yang mempunyai nilai ekonorni cukup tinggi dan merupakan tanaman yang selalu diusahakan oleh para petani sebagai tanaman sela. Pendapatan masyarakat semakin meningkat clan kesadaran terhadap nilai kesehatan juga semakin meningkat, maka permintaan buah pisang semakin tinggi. Hal ini meningkatkan rninat para petani di pedesaan untuk lebih intensif membudidayakan tanaman pisang, baik sebagai tanaman sela maupun dibudidayakan secara monokukl-tur (Sudana et al., 2000). Tanaman pisang di beberapa daerah telah mengalarni kerusakan akibat serangan patogen penyebab penyakit layu yakni Pseudomonas solanacearum dan Fusarium oxysporum £sp. cubense (Semangun, 1989). Berdasarkan pengamatan penulis, dari kedua patogen tersebut yang umum ditemukan di daerah Bali adalah F. oxysporum £sp. cubense (Foe).
Budidaya pertanian pada beberapa dekade tahun terakhir sangat tergantung terhadap penggunaan agrochemical (zat kimia sintetis), sebagai metode yang dapat dipercaya untuk perlindungan tanaman dengan stabilitas ekonorni menyangkut operasinya. Kenaikan penggunaan input zat kimia mengakibatkan beberapa pengaruh negatif, seperti : meningkatkan ketahanan patogen clan berdampak terhadap pencemaran lingkungan. Oleh karena itu perlakuan alternatif diperlukan dalam halpengendalian penyakit tumbuhan. Pemanfaatan rnikroorganisme untuk mengendalikan patogen tumbuhan, dikenalsebagaipengendalianhayati (biological control) yang sekarang sedang diterapkan. Hal ini dapat diterima sebagai pengendalian alternatif yang cocok clan ramah lingkungan a.tau langkah tambahan untuk menurunkan penggunaan zat kirnia
sintetis dalam bidang pertanian dalam menghadapi pengelolaan penyakit tumbuhan ( Anitha clan Rabeeth, 2009). Pengendalian hayati dengan memanfaatkan Streptomyces spp. telah banyak dilakukan terhadap biji, bibit clan media tanam untuk menurunkan patogen rebah kecambah clan patogen tular tanah ( Soil borne pathogen) (Lahdenpera, 2000).
Seleksi mikroorganisme untuk memproduksi antibiotik berguna telah dilakukan secara terus menerus dengan intensif oleh para ilmuwan. Antibiotik telah banyak digunakan dalam bidang pertanian, peternakan clan industri farmasi. Actinomycetes telah mampu mensintesis banyak senyawa aktif yang berbeda-beda berupa metabolit sekunder, yakni : antibiotik, herbisida, pestisida, antiseptik, clan enzim seperti selulase, xylanase dan digunakan dalam perlakuan sampah (Os-kay et al., 2004). Kemampuan beberapa isolat Actino-mycetes sebagai mikroba antagonis perlu diuji untuk mengendalikan Foe.
METODOLOGI PENELITIAN
Isolasi Fusarium oxysporumf sp. cubense
Patogen diisolasi dari pisang yang bergejala layu Fusarium yang berlokasi di sentra penanaman pisang di Bali. Setiap tanaman yang bergejala sakit batang semunya diambil dimasukkan dalam plastik, kemudian di label untuk diamati di laboratorium. Isolasi patogen dilakukan dengan memotong bonggol atau batang palsu pisang sakit kira-kira 1 x 1 cm, setelah itu dicelupkan dalam Beaker glass yang berisi alkohol 70% selama dua menit untuk menghilangkan kontarninasi pada bagian luarnya, kemudian dibilas dengan mencelupkannya ke dalam akuades steril sebanyak tiga kali. Potongan bonggol/batang sakit diletakkan pada media PDA
Isolat AAo4
( Streptomyces sp. l)
Isolat AAo32
( Streptomyces sp.2)
Isolat AAo33
( Streptomyces sp.3
Isolat AAo35
( Streptomyces sp.4)
Gambar 1. Uji awal antagonistik Streptomyces spp. terhadap Foe
yang ^cbelurnnya telah diisi dengan antibiotik livoplo-saxin (0,5%) dan diinkubasikan selama tiga hari pada suhu kamar. Bentuk spora (rnikrokonidia, makroko-nidia clan klarnidospora) dilihat di bawah rnikroskop dan difoto.
Isolasi Streptomyces spp.
Media tumbuh Aetinomyeetes yang digunakan adalah media KenKnight yang terdiri dari : dextrose lg, KH2P04 O,lOg, NaN03 O,lOg, KC10,10g,MgS04 7 H20 O,lOg, agar 15 g dan Aquadest 1000 ml (Rao, 1994), antibiotika nystatin (penghambat jamur) (0,15%).
Tarrah sampel yang diambil kemudian dilakukan pengeneeran yang diulang 3 kali (3 piring Petri), kemudian dihitung jumlah eoloni (cfu = colony forming unit). Isolasi Actinomyeetes dengan jalan 10 g tanah yang diambil dari habitat tanaman pisang sehat, dilarutkan dalam 90 ml akuades diaduk seeara merata sehingga volume menjadi 100 ml, selanjutnya dilakukan pengeneeran untuk Aetinomyeetes 10-3 -10-s. Cairan diambil sebanyak 1 ml untuk dipindahkan masing-masing ke dalam media KenKnight dan diinkubasikan selama 3 hari. Kelompok yang muneul merupakan jenis rnikroba, yang selanjutnya di lakukan perhitungan CFU (colony forming unit), dengan tiga kali ulangan. Identifikasi bakteri dan actinomyeetes dengan uji Bergey's Manual of Determinative Bacteriology (Holt et al., 1994); dan Atlas Aetinomyeetes yang diakses dari internet. Seanjutnya untuk membandingkan apakah jumlah Aetinomyeetes lebih banyak pada habitat tanaman pisang dengan dan tanpa gejala layu Fusarium dilakukan uji Chi kuadrat.
Kalani yang tumbuh dimurnikan untuk mengisolasi Streptomyces, kemudian ditumbuhkan dalam media miring dari PDA ((kentang 200 g, gula 15 g, agar 20 g dalam I liter aquadest). Setelah berumur 2 - 3 minggu diidentifikasi dilihat di bawah rnikroskop, selanjutnya difoto.
Uji antagonis antara Streptomyces spp dengan Foe
Uji antagonis dilakukan tiga tahap, yakni : ( 1) uji awal antagonis untuk seluruh Aetinomyeetes yang
did.ipat terhadap Foe, (II) Bioassay uji antagonis dengan ulangan 3 kali Streptomyces spp. terhadap Foe, (III) uji antagonis Streptomyces spp. terhadap Foe yang berasal dari beberapa kultivar pisang di Bali. Daya hambat dapat dihitung dengan menggunakan rumus, yakni : diameter koloni kontrol dikurangi dengan diameter koloni perlakuan dibagi dengan diameter koloni kontrol kali 100%.
HASIL DAN PEMBAHASAN
Sebanyak 69 isolat Aetinomyeetes dapat diisolasi dari habitat tanaman pisang tanpa gejala layu Fusarium dan habitat tanaman pisang dengan gejala layu Fusarium sebanyak 50 isolat (Tabel 1). Setelah diadakan pemurnian dan uji identifikasi diketahui hanya 4 isolat Streptomyces spp. bersifat antagonis yang berasal dari habitat tanaman tanpa gejala layu Fusarium, yakni isolat AAo4 ( Streptomyces sp. 1), AAo32 (S treptomyces sp. 2), AAo33 (Streptomyces sp.3) dan AAo35 (Streptomyces sp. 4). Keempat isolat kemudian dilakukan uji awal antagonis terhadap Foe, kelihtan ada zone hambatan yang merupakan senyawa antibiotik dikeluarkan oleh Streptomyces spp. dengan daya hambat masing-masing sebesar 77,78%, 77,78%, 83,33% dan 80% (Gambar 1).
Actinomyeetes merupakan mikroorganisme prokaryot yang merniliki kandungan G+C tinggi dalam DNAnya, dengan menghasilkan metabolik yang beragam. Keragaman metabolik family Actinomyeetes diakibatkan oleh sejumlah besar genomnya, yang merniliki ratusan faktor transkripsi yang mengendalikan ekspresi gen, sehingga memungkinkan mereka merespon terhadap kebutuhan spesifik (Singh et al., 2006).
Hasil bioassay (uji antagonis) dengan ulangan 3 kali, keempat : isolat AAo4 (S treptomyces sp.1), AAo32 (Streptomyces sp.2), AAo33 (Streptomyces sp. 3) clan AAo35 Streptomyces sp.4), memiliki daya hambat masing-masing 79.63 ± 3.20%, 72.22 ± 5.56%, 78.89 ± 1.92 dan 72.22 ± 0% (Gambar 2). Streptomyces merupakan genus paling besar menghasilkan antibiotik dibandingkan dengan genus yang lain dari Ac-tinomyetes (Ningthoujam et al., 2009). Diperkirakan
Tabel 1. Jenis Actinomycetes yang ditemukan hasil isolasi dan identifikasi pada tanah sampel habitat tanaman pisang dengan dan tanpa gejala layu Fusarium
|
Jenis mikroba |
Jumlah jenis Actinomycetes pada lokasi tanah sampel** | |||||
|
Ao |
As |
Bo |
Bs |
Co |
Cs | |
|
Actinomycetes | ||||||
|
Actinomyces sp. |
1 |
1 |
* |
* |
* |
• |
|
Actinop/anes sp. |
* |
- |
1 |
2 |
- |
- |
|
Agromyces sp. |
1 |
- |
1 |
- |
- |
- |
|
Dactylosparangium sp. |
1 |
3 |
- |
* |
• |
3 |
|
Frankia sp. |
2 |
- |
* |
2 |
* |
1 |
|
Geodermataphilus sp. |
- |
- |
- |
• |
• |
2 |
|
Micrabispora sp. |
• |
• |
1 |
* |
1 |
- |
|
Micromonaspora sp. |
- |
4 |
4 |
1 |
6 |
7 |
|
Nocardia sp. |
19 |
1 |
3 |
4 |
4 |
- |
|
Pilimelia sp. |
• |
-- |
* |
1 | ||
|
Pseudonocardia sp. |
1 |
- |
• ∙ |
• |
- | |
|
Sacharomonospora sp. |
- |
* |
5 |
12 |
- |
- |
|
Streptomyces sp.l |
1 |
5 |
2 |
• |
2 |
* |
|
Streptomyces sp.2 |
1 |
- |
- |
- |
- |
- |
|
Streptomyces sp.3 |
1 |
- |
- |
- |
* |
- |
|
Streptomyces sp.4 |
4 |
- |
* |
* | ||
|
Streptosporangium sp. |
2 |
- |
2 |
1 |
2 |
1 |
|
Jumlah individu |
34 |
14 |
19 |
22 |
16 |
14 |
Jumlah jenis 11 5 8 6 6 5
•• Jumlah individu dan jenis Actinomycetes pada lokasi tanaman pisang tanpa gejala layu Fusarium lebih banyak sangat nyata dibandingkan dengan pada habitat tanaman pisang bergejala layu Fusarium dengan uji Chi kuadrat (P<l%).
Keterangain
Tanah sampel yang diambil dari habitat tanaman pisang tanpa gejala layu Fusorium (tanah supresif)
Ao ; Desa Pesedahan-Karangsem, Bo; Desa Pesinggahan-Klungkung, dan Co ; Desa YehsumbulJ embrana. Tanah sampel yang diambil dari habitat tanaman pisang dengan gejala layu Fusorium (tanah kondusif) : As; Desa Buitan-Karangsem, Bs; Desa Belatung-Klungkung dan Cs; Desa Pekutatan-Jembrana.
80% produk antibiotik dihasilkan oleh Streptomyces (Singh et al., 2006). Streptomyces sebagai mikroba prokaryotik diketahui memegang peranan penting dalam siklus nutrisi, fiksasi nitrogen, produksi metabolik sekunder clan memacu pertumbuhan tanaman. Di dalam memacu pertumbuhan tanaman dapat terjadi baik secara langsung maupun tidak langsung. Secara langsung termasuk menghasilkan fitohormon, fosfat terlarut, fiksasi nitrogen clan menaikkan pengambilan nutrisi. Secara tidak langsung dapat mengendalikan patogen melalui produksi metabolik sekunder, kompetisi, parasitisme, clan menginduksi ketahanan (Barreto et al., 2008). Patogen (Foe) yang mengalami tekanan akibat antibiotik yang dikeluarkan oleh Streptomyces sp. (Oskay et al., 2004). Jamur ini cendrung akan membentuk spora sebagai alat untuk bertahah hidup seperti klamidospora. Berdasarkan hasil pengamatan di bawah mikroskop terlihat sejumlah klamidospora, sedikit ditemukan mikrospora clan tidak terlihat adanya makrospora (Gambar 3 ).
Hasil uji antagonis keempat isolat Streptomyces spp. terhadap Foe yang berasal dari beberapa kultivar pisang, menunjukkan bahwa keempat isolat tersebut mampu menghambat pertumbuhan Foe secara in vitro. Daya hambat keempat isolat kultivar Streptomyces spp. bervariasi terhadap Foe yang berasal dari empat kulti-var. Paling tinggi daya hambat keempat isolat terlihat

Garnbar 3. Perbandingan pertumbuhan Foe setelah diuji antagonis (A), dan tanpa perlakuan (B)
pada Foe asal kultivar Saba, diikuti Raja, Ketip clan yang paling kecil daya hambatnya pada kultivar pisang Susu (Tabel 2).
Tabel 2. Uji antagonis Streptomyces spp. terhadap Foe yang berasal dari berbagai kultivar pisang
|
lsolat Streptomyces spp. |
Daya hambat Streptomyces spp. terhadap Foe yang berasal dari berbagai kultivar pisang (%) | ||
|
Susu |
Saba |
Raja Ketip | |
|
AAo4 (Streptomyces sp. 1) |
79,63 ± 3,20 |
80,74 ± 2,56 |
81,11± 2,94 83,33 ± 5,57 |
|
AAo32 (Streptomyces sp. 2) |
72,22±5,56 |
80 ±2,22 |
79,63±3,20 74,08± 6,41 |
AAo33 78,89 ± 1,92 80,74 ± 2,79 76,3 ± 1,28 72,22± 5,56
(Streptomyces sp. 3
AAo35 72,22 ± 0 81,48 ± 3,2 82,59±1,28 77,04± 1,28
(Streptomyces sp.4)
Hasil penelitianAnitha clan Rabeeth (2009) dengan menggunakan Strepomyces griseus yang diformulasikan dalam bentuk tepung clan diberikan sebelum infeksi olehF. oxysporum f sp. lycopersici. (FOL) pada tanaman tomat dapat menurunkan intensitas penyakit. Lebih jauh dijelaskan oleh Lahdenpera (2000), mekanisme penghambatan patogen tanaman oleh S. griseoviridis yakni : ( 1) melalui kompetisi yang terjadi di rhizosfer. Umumnya Streptomyces memiliki kemampuan kompetisi yang buruk dalam tanah, tetapi apabila berada pada tanah yang lembab terutama pada zone rhizos-fer, mereka akan menggunakan eksudat akar secara baik untuk pertumbuhannya. (2) Hiperparasitisme, jamur S. griseoviridis dapat mempenetrasi dinding miselium jamur patogen Pythium, Rhizoctonia solani clan Fusarium oxysporum. Enzim pemecah dinding sel diperlukan dalam hiperparasitisme. Jamur S. griseo-viridis menghasilkan enzim ekstraseluler. (3) Eksresi auxin, S. griseoviridis menghasilkan indole-3-acetic acid (IAA) secara in vitro. Metabolit ini dapat memacu pertumbuhan tanaman. (4) menghasilkan senyawa metabolit antimikroba. S griseoviridis menghasilkan senyawa heptaene polyene aromatic yang menghambat pertumbuhan jamur patogen, tetapi peranan senyawa ini terhadap pengendalian penyakit belum sepenuhnya diketahui.
I
SIMPULAN
Sejumlah 119 isolat actinomycetes yang terdiri dari 69 isolat berasal dari tanah sampel habitat tanaman pisang tanpa gejala layu Fusarium, dan 50 isolat yang berasal dari habitat tanaman pisang dengan gejala layu Fusarium. Dari keseluruhan isolat hanya 4 isolat yang menunjukkan kemampuan antagonis terhadap Foe. Semua berasal dari habitat tanaman pisang tanpa gejala layu Fusarium. Keempat isolat tersebut teridentifikasi yakni isolat AAo4 (Streptomyces sp.1), AAo32 (Strep-tomyces sp.2), AAo33 ( Streptomyces sp. 3) dan AAo35 (Streptomyces sp. 4). Kemampuan antagonis keempat isolat terhadap Foe yang berasal dari empat kultivar pisang yang terserang Foe, menunjukkan daya hambat yang hampir sama.
UCAPAN TERIMA KASIH
Ucapan terima kasih ditujukan kepada Bapak Prof. Dr. Ir. Dewa Ngurah Suprapta, MSc. selaku Ketua Laboratorium Biopestisida, Fakultas Pertanian Universitas Udayana, atas bantuan yang diberikan selama penulis mengadakan penelitian.
DAFTARPUSTAKA
Anitha, A. and M. Rabeeth. 2009. Control ofFusarium Wilt of Tomato by Bioformulation of Streptomyces griseus in Green House Condition. AfricanJournal ofBasic & Applied Sciences 1 (1-2): 9-14.
Barreto, T.R., A.C.M. da Silva, A.C. F. Soares andJ.T. de Souza. 2008. Population Densties and Genetic Diversity ofAc-tinomycetes Associated to the Rhizosphere ofTheobroma cacao. BrazilianJournal ofMicrobiology. 39: 464-470.
Holt,J.G., N.R. Krieg, P.H.A. Sneath,J.T. Staley, S.T. Williams. 1994. Bergey's Manual of Determinative Bacteriology. Ninth Edition. Lipincott Williams & Wilkins. Pp. 787. H.
Lahdenpera, M.L. 2000. How Mycostop acts in the control of fungal plant diseases. Infoletter. Verdera. 5: 1-2.
Ningthoujam, D.S., S. Sunasam and S. Nimaichand. 2009. AmericanJournal of Biochemestry ang Biotechnology. 5(4) : 221-225.
Oskay, M.,A. U. Tamer and C.Azeri. 2004. Antibacterialactivity ofsome actinomycetes isolated from farming soils ofTur-key. AfricanJournal ofBiotechnology. 3(9) : 441-446.
Oskay, M., 0. U. Tamer and C.Azeri. 2004.Antibacterial activity ofsome actinomycetes isolatedfrom farming soils ofTur-key. AfricanJournal ofBiotechnology. 3(9): 441-446.
Rao, N.S.B. 1994. Mikoorganisme Tanah dan Pertumbuhan Tanaman. Edisi kedua. Penerbit Universitas Indonesia. (Ul-Press). 353 h.
Semangun, H. 1989. Penyakit-penyakit PentingTanaman Hortikultura di Indonesia. Gadjah Mada Press. Yogyakarta.
Singh, L.S., I. Baruah and T.C. Bora. 2006. Actinomycetes of Loktak Habitat : Isolation and Screening for Antimicrobial Activities. Biotchnology. 5(2): 217-221.
Sudana, M., D.N. Suprapta, N. Arya dan G.P. Wirawan. 2000. Penelitian Pengendalian Penyakit Layu Tanaman Pisang Tersebar di 9 (Sembilan) Kabupaten/Kota di Bali. Ker-jasana antara Dinas Pertanian Tanaman Pangan Provinsi Bali dengan Fakultas Pertanian UniversitasUdayana. Fak. Pertanian Unud. Denpasar. 44 h.
107
Discussion and feedback